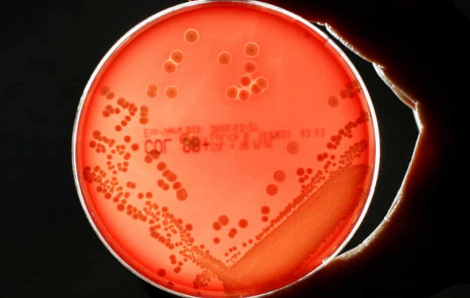
Siêu vi khuẩn có thể giết chết hàng triệu người
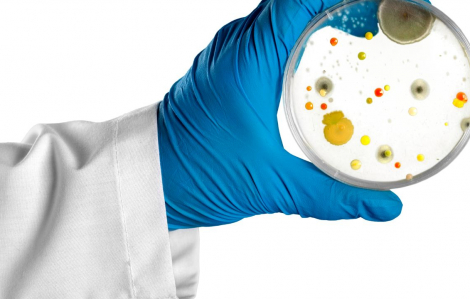
39 triệu người có nguy cơ tử vong do siêu vi khuẩn kháng thuốc

Kết quả tìm kiếm cho "sieu vi khuan khang thuoc"
Kết quả 1 - 12 trong khoảng 12
Nghiên cứu về gánh nặng kháng thuốc kháng sinh ở 122 quốc gia, dự đoán những kết quả kinh tế và sức khỏe thảm khốc.

Các nhà khoa học ở Tel Aviv giới thiệu loại vắc-xin mới sử dụng công nghệ mRNA, kết quả thử nghiệm trên động vật cho thấy hiệu quả 100%.

Một phân tích toàn cầu dự đoán rằng tình trạng nhiễm siêu vi khuẩn kháng thuốc có thể giết chết gần 40 triệu người trong 25 năm tới;
Một dự án nghiên cứu toàn cầu về kháng kháng sinh cảnh báo rằng, các loại siêu vi khuẩn có thể giết chết hơn 39 triệu người trước năm 2050.

Ngày 16/9, một phân tích toàn cầu dự đoán rằng tình trạng nhiễm siêu vi khuẩn kháng thuốc có thể giết chết gần 40 triệu người trong 25 năm tới.

Kháng kháng sinh, một tình trạng bệnh lý nghiêm trọng, khiến hơn 1 triệu người phải ra đi mỗi năm. Nhiều nạn nhân trong số này là trẻ em.

Các chuyên gia y tế Anh cảnh báo, tình trạng kháng thuốc do lạm dụng kháng sinh có thể dẫn đến hàng triệu ca tử vong do nhiễm trùng thông thường.

Tổ chức Y tế Thế giới cho biết kháng thuốc là một trong những mối đe dọa sức khỏe toàn cầu hàng đầu trong thời gian tới.

Mỗi ngày, thế giới có trung bình gần 2.000 người chết vì siêu vi khuẩn kháng thuốc; con số tử vong có thể tăng lên gấp 15 lần vào năm 2050.
Thuốc kháng sinh là một công cụ chữa bệnh nhiễm khuẩn hữu hiệu, tuy nhiên tình trạng lạm dụng thuốc đã đặt con người trước nguy cơ kháng thuốc ngày càng trầm trọng.

Các bác sĩ nhận định sức khỏe bé N.T.N.Y. rất xấu: viêm phổi nặng, nhiễm trùng máu, nhiễm nấm huyết, tràn mủ màng phổi phải.

Kết quả nghiên cứu cho thấy, xe đẩy siêu thị chứa lượng vi khuẩn nhiều gấp 361 lần cần gạt nước nhà vệ sinh.